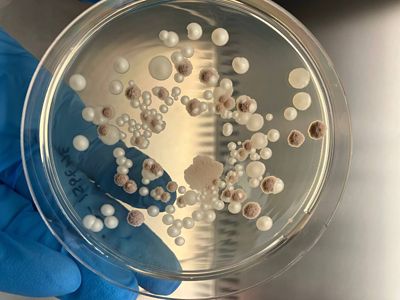
dati analitici del laboratorio

Strategie e strumenti innovativi per l'insilamento
Pubblicato su Allevatori Top, n 6/2024
L’utilizzo di additivi microbiologici ad azione specifica garantisce la massima conservazione dei nutrienti presenti e al tempo stesso la massima stabilità durante il consumo, con un miglior impatto sulla sanità del prodotto.
Il processo di insilamento è la migliore pratica di conservazione che permette di preservare al meglio il valore nutrizionale e l’appetibilità dei foraggi all’interno dei sistemi di razionamento dei bovini da carne e da latte in virtù delle condizioni di pH e di anaerobiosi che si vengono a creare durante il processo. Le attuali tecnologie permettono di adattare i sistemi di conservazione alle esigenze di ogni azienda; oltre a sistemi di stoccaggio orizzontali (trincee e cumuli), è sempre più comune l’utilizzo di silobag o balloni ad alta densità, che rendono possibile una conservazione ottimale anche in assenza di strutture dedicate.
Campionamento ed analisi di insilati a bordo del laboratorio mobile Corteva
Scelte importanti
Il buon risultato del processo di insilamento, come ormai noto, è soggetto ad un elevato numero di variabili operative che si succedono dal momento della raccolta fino alla chiusura del silo. La corretta scelta del momento di trinciatura rappresenta la prima variabile che incide sulla qualità del prodotto in relazione alla destinazione (zootecnico o bioenergetico). Contestualmente va garantito un processo di riempimento della trincea e un compattamento con macchine adeguate al tempo e al volume di lavoro, al fine di raggiungere un livello di compattamento che impedisca la presenza e l’ingresso di ossigeno all’interno del silo. Per finire, la chiusura del silo, che deve essere effettuata con tempistiche opportune e teli adeguati. Mentre tutti questi aspetti “macroscopici” sono gestiti direttamente dagli agricoltori, il successo del processo di insilamento dipende soprattutto da un fattore “microscopico”, o meglio microbiologico, perché è legato a quei microrganismi che convertono gli zuccheri in acidi organici, necessari e indispensabili per la corretta conservazione dei foraggi in ambiente anaerobico: i batteri lattici. Questi microrganismi, che di norma possono trovarsi sulla flora epifitica delle piante al momento della trinciatura, appartengono a specie e ceppi molto eterogenei, e con metabolismi molto differenti, che permettono loro di utilizzare zuccheri diversi o produrre metaboliti diversi. Si parla ad esempio di batteri omo-fermentanti ed etero-fermentati, facoltativi od obbligati. La loro numerosità sulla pianta è strettamente correlata alle condizioni ambientali in cui si sviluppa la coltura durante il proprio ciclo vegetativo, con valori che, secondo letteratura, possono oscillare dai 103 e 106 UFC (unità formanti colonia).
Ceppi selezionati
Per ovviare alla variabilità numerica e all’eterogeneità specifica dei batteri naturalmente presenti sulla coltura, l’impiego di additivi microbiologici contenenti ceppi batterici selezionati in base alle loro caratteristiche metaboliche è diventata una pratica sempre più consolidata nel corso degli anni. L’inoculazione durante la trinciatura, oltre a garantire una presenza numerica adeguata di batteri favorevoli, può fornire un vero e proprio “valore additivo” alla massa insilata. La combinazione di batteri che agiscono con fermentazione di tipo omolattico – come Lactobacillus plantarum – ed eterolattico – come Lactobacillus buchneri – permette infatti di fornire alla massa insilata un duplice effetto derivante dal trattamento microbiologico: una acidificazione più rapida, funzionale alla conservazione e una superiore capacità di stabilizzare il fronte durante il desilamento e l’utilizzo in mangiatoia, evitando così deterioramenti aerobici.
Non tutti i ceppi batterici sono però uguali. Se inizialmente l’applicazione di batteri lattici poteva comportare solo una maggiore efficacia del processo di acidificazione, adesso è pratica comune sfruttare l’utilizzo combinato di metabolismi selezionati, ma compatibili fra loro, per garantire anche una maggiore stabilità aerobica durante il consumo grazie ad adeguate produzioni di acido acetico. I più moderni e innovativi ritrovati nell’ambito microbiologico si spingono addirittura oltre: grazie a ceppi batterici specifici e brevettati, si possono ottenere insilati stabilizzati già nell’arco di alcuni giorni per rispondere, ad esempio, all’esigenza di approvvigionarsi in tempi rapidi, ma che permettono anche con aperture convenzionali di conservare più nutrienti rispetto ad un additivo tradizionale. Altre tecnologie, invece, utilizzano batteri in grado di produrre enzimi che vanno a lavorare in modo mirato sui legami tra lignina e cellulosa, aumentando la digeribilità della fibra.
Corteva Agriscience ha attivato presso i propri laboratori un servizio di analisi microbiologica di foraggi freschi, insilati e unifeed.
Efficacia misurabile
L’efficacia di questi additivi può essere misurabile e correlabile alla capacità di contrastare la proliferazione di lieviti e muffe durante il consumo e l’utilizzo degli insilati durante la stagione, ma i parametri più misurabili sono il pH, gli acidi organici e qualche metabolita del processo che agisce da marker (ammoniaca, etanolo, mannitolo, ecc.). Recentemente la società Corteva Agriscience ha attivato presso i propri laboratori un servizio di analisi microbiologica di foraggi freschi, insilati e unifeed grazie al quale è possibile monitorare i principali microrganismi coinvolti nel processo di conservazione. I dati emersi durante il primo anno di monitoraggio sono risultati molto chiari per misurare l’efficacia degli additivi microbiologici a marchio Pioneer. Considerando i campioni di silomais raccolti durante la scorsa annata, è stato possibile valutare come negli insilati trattati rispetto ai non trattati, la contaminazione sia mediamente 10 volte più bassa per i lieviti e 100 volte per le muffe, che può tradursi mediamente in un incremento di ingestione di sostanza secca di circa 150/200 grammi ogni 3 ore di alimentazione (grafico 1). Altro importante dato raccolto riguarda l’effettiva presenza di batteri lattici, muffe e lieviti presenti durante l’accrescimento del mais durante la stagione. Rispetto a muffe e lieviti, i batteri lattici risultano più sensibili agli stress ambientali e sono quindi soggetti a importanti riduzioni della propria vitalità in caso di eventi atmosferici anomali. Muffe e lieviti, viceversa, mantengono costante la loro capacità di proliferare. L’utilizzo di additivi con tecnologie innovative, ad azione specifica, sia per effetto che per tipo di prodotto, rappresentano una strategia vincente per valorizzare davvero al massimo gli insilati, garantendo contemporaneamente la massima conservazione dei nutrienti con il massimo della stabilità durante il consumo, con un miglior impatto sulla sanità dei prodotti conservati.
Grafico 1:
Campagna 2023: negli insilati trattati con gli additivi microbiologici di Pioneer, la presenza di muffe è mediamente 100 volte inferiore rispetto al controllo.